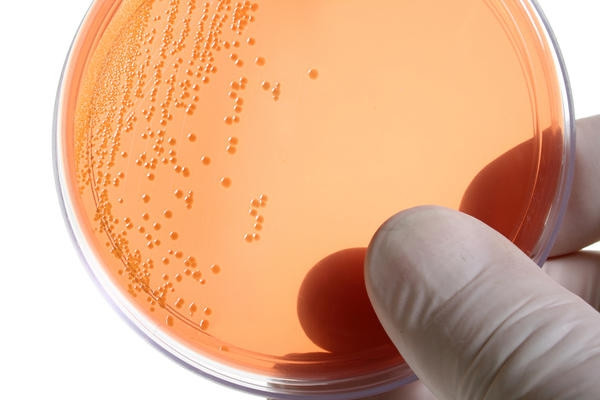
лечение хламидиоза

Среди многочисленных инфекций, передающихся половым путем, одной из самых распространенных считается урогенитальный хламидиоз. Количество пациентов с таким заболеванием из года в год растет. Это связано с увеличением числа незащищенных половых связей, стертыми симптомами заболеваниями и сложной диагностикой. Усугубляет проблему появление штаммов, которые устойчивы к антибиотикам, что вызывает сложности в лечении заболевания.
Способы заражения
Chlamydia trachomatis – самый распространенный вид бактерий, который является причиной развития хламидиоза.

Она становится возбудителем заболевания при попадании в организм, что происходит обычно несколькими способами:
- Половым путем – в результате незащищенного полового акта с носителем заболевания.
- Внутриутробным путем.
- Контактно-бытовым – этот вариант передачи недуга встречается крайне редко.
При попадании бактерии в организм она сразу проникает в клетки, так как вне них она не способна размножаться и расти. Внутри клеток бактерия может выживать на протяжении длительного времени, особенно в случае неграмотного лечения.
Цикл размножения бактерии – в среднем 2-3 суток. После этого клетка разрушается, а хламидия переходит в другие клетки. Такая активность позволяет бактериям поражать даже клетки крови, что усложняет лечение заболевания. Ведь при попадании в клетки крови бактерия активно разносится по всему организму и хламидиоз переходит в стадию хронического.
Врачи подчеркивают, что урогенитальный хламидиоз часто протекает бессимптомно, что делает его особенно опасным. Основные симптомы, на которые стоит обратить внимание, включают болезненное мочеиспускание, выделения из половых органов и дискомфорт в области таза. При отсутствии лечения инфекция может привести к серьезным осложнениям, таким как воспалительные заболевания органов малого таза и бесплодие.
Специалисты рекомендуют регулярные обследования, особенно для людей с повышенным риском. Лечение обычно включает антибиотики, которые эффективно устраняют инфекцию. Важно завершить курс лечения и пройти повторное обследование, чтобы убедиться в отсутствии инфекции. Врачи также акцентируют внимание на необходимости информирования половых партнеров, чтобы предотвратить повторное заражение. Профилактика, включая использование барьерных методов контрацепции, играет ключевую роль в снижении риска заражения.
https://youtube.com/watch?v=fYEUV8YUkrw
Симптомы заболевания у женщин
При развитии урогенитального хламидиоза поставить диагноз порой невероятно сложно. Дело в том, что симптомы могут быть как ярко выраженными, так и совершенно размытыми. У многих пациентов заболевание не проявляется, клинические симптомы отсутствуют, что приводит к постепенному переходу недуга в хроническую стадию.
Проблема отсутствия симптомов обычно относится к женщинам. Субъективные симптомы встречаются у 25% женщин, страдающих хламидиозом. Поэтому на малейшие проявления болезни нужно сразу же обращать внимание.
Симптомы хламидиоза у женщин выделяют следующие:
- Серозно-гнойные выделения из половых путей. Иногда можно отметить примеси крови.
- Кровотечение после сексуального контакта или маточное кровотечение, не связанное ни с чем.
- Болевые ощущения без причин в области малого таза.
- Ощущение тяжести в области лобка.
- Протоки уретры воспаляются.
- Воспаление бартолиниевых желез, которые находятся около влагалища.

Симптомы заболевания у мужчин
В отличие от женщин, признаки у мужчин обычно явно выражены. Проявляются первые симптомы обычно за несколько недель, максимум спустя месяц после заражения.
Самыми распространенными симптомами, на которые стоит моментально обратить внимание, считают следующие:
Обычно клинические симптомы имеют характер слабо и средневыраженный. У некоторых мужчин симптомы отсутствуют или являются эпизодическими, поэтому пациенты им не придают никакого значения
Урогенитальный хламидиоз — это инфекция, вызываемая бактерией Chlamydia trachomatis, и она часто протекает бессимптомно, что затрудняет диагностику. Многие люди отмечают, что первые признаки могут проявляться в виде жжения при мочеиспускании, выделений из половых органов и болей внизу живота. Однако у женщин симптомы могут быть менее выраженными, что увеличивает риск осложнений, таких как воспалительные заболевания органов малого таза.
Лечение хламидиоза обычно включает антибиотики, такие как азитромицин или доксициклин. Важно, чтобы оба партнера прошли курс лечения, чтобы избежать повторного заражения. Многие пациенты подчеркивают важность регулярных обследований, особенно для активных сексуальных партнеров, так как ранняя диагностика и лечение значительно снижают риск осложнений. В целом, осведомленность о симптомах и методах лечения может помочь в борьбе с этой распространенной инфекцией.
https://youtube.com/watch?v=fkeQHb7Z8-o
Диагностика хламидиоза
Для диагностики урогенитального хламидиоза доктор проводит осмотр. Во время осмотра женщин наблюдаются некоторые изменения, а именно:
Чтобы поставить диагноз медики в обязательном порядке назначают лабораторные исследования, которые позволяют точно определить наличие возбудителя в клетках организма.

Какие анализы сдают для диагностики хламидиоза
Для проведения лабораторных исследований у пациентов берут образцы крови, содержимое половых путей, соскобы. У мужчин образцы для исследований из уретры получают путем введения специального тампона на 2-4 см.
Для диагностики хламидиоза у женщин делают мазок из цервикального канала при помощи специальной щетки. Но сначала удаляют слизистую пробку, благодаря чему повышается вероятность определения бактерии возбудителя.
Современная медицина выделяет несколько видов лабораторной диагностики заболевания, передающего половым путем:
- Цитологическое исследование – возбудитель стараются обнаружить под микроскопом. Такой метод все еще применяется в медицине, несмотря на низкую вероятность обнаружения бактерий. Результативность метода отмечена на уровне 10%.
- Имуннофлюоресцентное исследование – при проведении такого анализа мазки окрашивают антихламидийными антителами, в которые предварительно вводятся флуоресцентные компоненты. Методика дает хорошие результаты – до 95%, а также позволяет быстро определить наличие возбудителя в организме.
- Иммуноферментный анализ – его суть заключается в выявлении в организме специфического липополисахарида, который обычно присутствует при заражении пациента хламидиозом. Чувствительность анализа средняя – от 60 до 90%.
- Серологический анализ – определение присутствия антител против хламинов. При проведении такого исследования лаборанты пытаются найти в пробах присутствие иммуноглобулинов классов “M” и “G”. Правда, практика показывает, что результаты таких анализов могут быть как ложноположительными, так и ложноотрицательными – точным данное исследование назвать сложно.
- Метод молекулярно-биологический – позволит определить присутствие ДНК Chlamydia trachomatis в мазках или в моче. Этот метод отличается высокой чувствительностью, но ввиду того, что есть риск загрязнения реагентов от других образцов, встречаются ложноположительные или ложноотрицательные результаты
Ни один из перечисленных лабораторных методов не позволяет говорить о 100% точности результата, медики сегодня практикуют проведение нескольких анализов для точной диагностики заболевания.
Лечение недуга
Для избавления от урогенитального хламидиоза используют в основном антибактериальные препараты. Ведь возбудитель проблемы —, бактерия. Медики отмечают наибольшую эффективность антибиотиков, которые относятся к группе макролидов. Они эффективно воздействуют на микроорганизмы.
Из этой группы антибиотиков особой эффективностью может похвастаться Сумамед. Препарат попадает в пораженные клетки, постепенно накапливается, поэтому в клетках вскоре наблюдается довольно высокая концентрация. Именно за счет этого медикамент устраняет бактерию в местах локализации. Достаточная концентрация лекарства достигается после одной таблетки, а сохраняется неделю.
Принимать Сумамед нужно с осторожность, так как препарат может провоцировать дисфункцию кишечника, быть причиной сбоев в работе печени. Есть риск развития аллергических реакций. Если некоторые из перечисленных симптомов возникают у пациента, врач подбирает другой препарат, принимая во внимание индивидуальную переносимость человека.
В случае хронической формы хламидиоза наблюдаются в организме иммунные нарушения. В таком случае необходимо дополнительно принимать иммуномодуляторы.
С особой осторожностью назначают препараты для лечения хламидиоза у женщин на разных сроках беременности.
Допускается прием следующих препаратов:
Эритромицин прекрасно себя зарекомендовал при лечении хламидиоза. Но назначать его в первом триместре беременности не рекомендуется.
При возникновении подозрения на хламидиоз, обследованию обязательно подлежат все партнеры. При выявлении заболевания хотя бы у одного партнера, все должны пройти лечение. При проведении диагностики и в период лечения доктора советуют воздерживаться от сексуальных контактов или использовать презервативы.
Прогноз лечения благоприятный, если заболевание своевременно выявлено и схема лечения назначена грамотно.

При отсутствии лечения или при выборе неэффективной схемы есть вероятность развития осложнений:
Меры для профилактики
Профилактика хламидиоза довольно проста:
- Избегать беспорядочных сексуальных контактов.
- Использовать презервативы.
- Регулярно проходить обследования мочеполовой системы.
- Обращать внимание на любые изменения в работе организма для своевременного выявления и быстрого лечения недуга, если его не удалось избежать.
Простые правила помогут оставаться здоровым.
https://youtube.com/watch?v=10Mj2xuaIBE
Вопрос-ответ
Как проявляется урогенитальный хламидиоз?
Слизистые или слизисто-гнойные выделения из влагалища (от нормальных выделений они могут отличаться неприятным запахом или желтоватым оттенком), дискомфорт (зуд и жжение) или боли во время мочеиспускания, несильные боли в области наружных и внутренних половых органов, боли в нижней части живота (в области малого таза).
Что такое урогенитальный хламидиоз?
Урогенитальный хламидиоз (Chlamydial Genitourinary Infections) — это инфекционное заболевание, вызываемое определенными серотипами Chlamydia trachomatis, передаваемое половым путем и поражающее преимущественно мочеполовую систему человека.
Советы
СОВЕТ №1
Регулярно проходите медицинские обследования. Урогенитальный хламидиоз может протекать бессимптомно, поэтому важно регулярно проверяться у врача, особенно если вы находитесь в группе риска.
СОВЕТ №2
Используйте средства защиты при половом акте. Презервативы значительно снижают риск передачи хламидий и других инфекций, передающихся половым путем, поэтому их использование крайне рекомендуется.
СОВЕТ №3
Не занимайтесь самолечением. Если у вас появились симптомы, такие как болезненное мочеиспускание или выделения, обратитесь к врачу для получения точного диагноза и назначения адекватного лечения.
СОВЕТ №4
Информируйте своих партнеров. Если у вас диагностирован урогенитальный хламидиоз, важно сообщить об этом своим половым партнерам, чтобы они также могли пройти обследование и лечение, предотвращая дальнейшее распространение инфекции.

